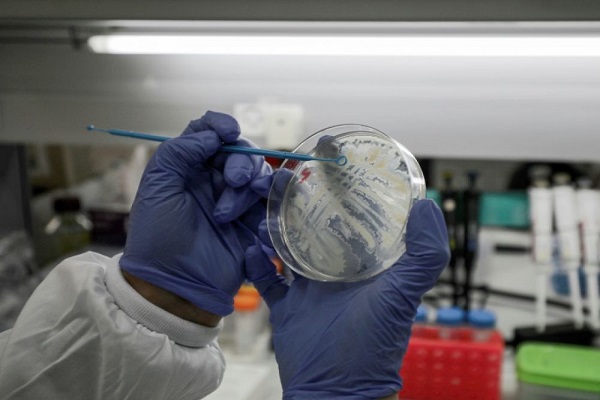
Les essais de l’hydroxychloroquine promue par Trump donnent de mauvais résultats

Les essais de l’hydroxychloroquine promue par Trump donnent de mauvais résultats
L’hydroxychloroquine, promue régulièrement par Donald Trump lors de ses points de presse quotidiens, n’a pas semblé améliorer le sort des malades américains atteints du Covid-19, selon une étude menée a posteriori sur ce médicament administré dans le monde entier, mais dont l’efficacité reste à confirmer ou infirmer.
L’étude préliminaire, rendue publique mardi par ses auteurs avant d’avoir été évaluée par le comité de lecture d’une revue médicale, porte sur 368 patients du réseau des hôpitaux publics pour anciens combattants américains, et qui sont soit morts, soit sortis d’hospitalisation avant le 11 avril, relate l’AFP.
Les auteurs ont analysé a posteriori les dossiers médicaux de ces patients, qu’ils ont groupés en trois groupes afin de les comparer: ceux traités avec de l’hydroxychloroquine seule (HC); ceux qui ont eu le cocktail hydroxychloroquine-azithromycine (un antibiotique) promu notamment par le professeur Didier Raoult, et ceux qui n’ont jamais reçu d’hydroxychloroquine.
La proportion de patients décédés a été la plus forte dans le groupe hydroxychloroquine seule (28%), comparée au groupe cocktail (22%) et au groupe sans HC (11%).
Mais cette conclusion peut être trompeuse car le groupe de malades n’ayant reçu que de l’hydroxychloroquine était, au départ, plus malade et plus à risque que les deux autres: il contenait plus de fumeurs et de personnes ayant du diabète ou des antécédents cardiovasculaires et pulmonaires.
Les auteurs ont corrigé statistiquement ce déséquilibre initial, et observé que «le risque accru de mortalité dans le groupe hydroxychloroquine seule persistait».
La spécificité des patients traités doit en outre conduire à la prudence sur toute généralisation à une population entière. Les patients étudiés étaient tous des hommes, en majorité noirs, une population plus durement frappée par l’épidémie aux États-Unis. L’âge médian était avancé: plus de 65 ans.
Plusieurs études en cours
L’hydroxychloroquine est l’un des traitements utilisés en urgence dans de multiples pays pour les cas graves de Covid-19, mais une controverse existe sur son impact.
L’idéal, scientifiquement, consiste à réaliser un essai clinique randomisé, où des groupes de malades comparables suivraient différents traitements de façon aléatoire.
De tels essais à grande échelle sont en cours, notamment l’essai européen Discovery, mais leurs résultats ne sont pas encore connus.
En attendant, les médecins expérimentent les molécules et traitements. Ils peuvent observer a posteriori les résultats, mais en l’absence de protocoles harmonisés sur la durée, les doses, les moments d’intervention, le degré de sévérité des cas au départ, il est difficile de tirer des conclusions fiables








